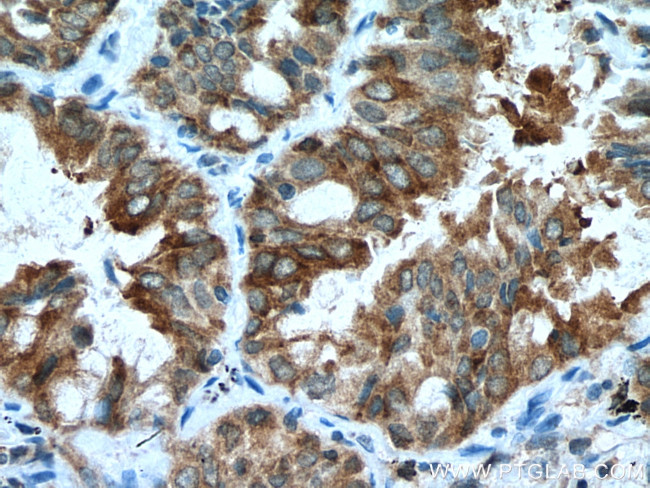
EPHB4 Antibody in Immunohistochemistry (Paraffin) (IHC (P))
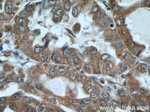
EPHB4 Antibody in Immunohistochemistry (Paraffin) (IHC (P))
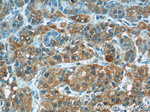
EPHB4 Antibody in Immunohistochemistry (Paraffin) (IHC (P))

Search
Proteintech
EPHB4 Polyclonal Antibody
{{$productOrderCtrl.translations['antibody.pdp.commerceCard.promotion.promotions']}}
{{$productOrderCtrl.translations['antibody.pdp.commerceCard.promotion.viewpromo']}}
{{$productOrderCtrl.translations['antibody.pdp.commerceCard.promotion.promocode']}}: {{promo.promoCode}} {{promo.promoTitle}} {{promo.promoDescription}}. {{$productOrderCtrl.translations['antibody.pdp.commerceCard.promotion.learnmore']}}
产品信息
20883-1-AP
种属反应
已发表种属
宿主/亚型
分类
类型
抗原
偶联物
形式
浓度
规格
纯化类型
保存液
内含物
保存条件
运输条件
产品详细信息
Immunogen sequence: KKESCVAIK TLKGGYTERQ RREFLSEASI MGQFEHPNII RLEGVVTNSM PVMILTEFME NGALDSFLRL NDGQFTVIQL VGMLRGIASG MRYLAEMSYV HRDLAARNIL VNSNLVCKVS DFGLSRFLEE NSSDPTYTSS LGGKIPIRWT APEAIAFRKF TSASDAWSYG IVMWEVMSFG ERPYWDMSNQ DVINAIEQDY RLPPPPDCPT SLHQLMLDCW QKDRNARPRF PQVVSALDKM IRNPASLKIV ARENGGASHP LLDQRQPHYS AFGSVGEWLR AIKMGRYEES FAAAGFGSFE LVSQISAEDL LRIGVTLAGH QKKILASVQH MKSQAKPGTP GGTGGPAPQY (639-987 aa encoded by BC052804)
靶标信息
EPHB4 is a receptor tyrosine kinase that belongs to the ephrin receptor family. Members of the Eph family of kinases play important roles in diverse biological processes including nervous system development, angiogenesis and neural synapsis formation and maturation. Based on their structures and sequence relationships, ephrins are divided into the ephrin-A (EFNA) class, which are anchored to the membrane by a glycosylphosphatidylinositol linkage, and the ephrin-B (EFNB) class, which are transmembrane proteins. The Eph family of receptors are divided into 2 groups based on the similarity of their extracellular domain sequences and their affinities for binding ephrin-A and ephrin-B ligands. Ephrin receptors make up the largest subgroup of the receptor tyrosine kinase (RTK) family. The protein encoded by EphB4 binds to ephrin-B2 and plays an essential role in vascular development.
仅用于科研。不用于诊断过程。未经明确授权不得转售。
生物信息学
蛋白别名: Developmental kinase 2; EPH receptor B4; ephrin receptor EphB4; Ephrin type-B receptor 4; Hepatoma transmembrane kinase; mDK-2; Tyrosine kinase MYK-1; tyrosine-protein kinase receptor HTK; Tyrosine-protein kinase TYRO11; unnamed protein product
基因别名: AI042935; CMAVM2; EPHB4; HFASD; HTK; LMPHM7; MDK2; MYK1; TYRO11
UniProt ID: (Human) P54760, (Mouse) P54761
Entrez Gene ID: (Human) 2050, (Rat) 686310, (Mouse) 13846